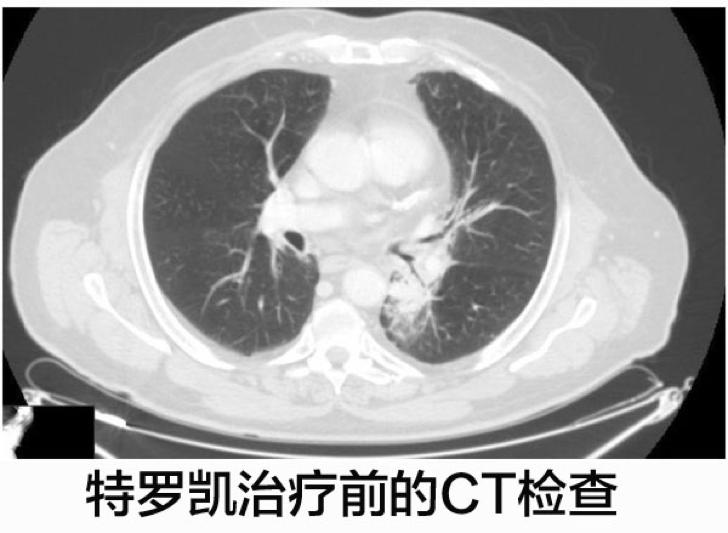
化疗失败后靶向药有效的案例,肺腺癌egfr突变耐药化疗

抗癌世界总是有一些奇怪的事情,比如EGFR基因突变的肺癌患者,原则上使用一代靶向药物易瑞沙、特罗凯,但是偏偏有部分病人没有效果。反过来,还有一部分病人,EGFR没有突变,但偏偏使用易瑞沙或者特罗凯有效。
今天给大家分享一个案例,一个EGFR阴性的肺腺癌患者,在化疗失败之后,使用特罗凯治疗达到了完全缓解,也就是所有可见的病灶都消失了,咱们一起来通过这个案例,看看究竟是什么原因。
一名67岁的高加索人,之前有重度吸烟史,因为持续咳嗽而入院。病人有缺血性心脏病、慢性阻塞性肺病、高血压病史。
经过CT影像学扫描显示左肺有一个33毫米×33毫米的实性结节,胸膜和肺血管出现了浸润。经过CT引导的穿刺活检显示为EGFR基因野生型的腺癌,由于病人具有慢性阻塞性肺病,肺部病变的根治性手术被排除在外。
既然EGFR基因是阴性,那就只能化疗了。当然我们不知道为何这个高加索人没有用二代测序多测几个基因,癌度前端时间的直播提示病友一定要尽可能测全面的基因,把驱动肿瘤发生的基因突变找到。原因我们不去推测了,就说这名高加索人一线使用顺铂、吉西他滨化疗了6个疗程,达到了部分缓解。
CT扫描显示病灶缩小为12毫米×30毫米,支气管周围的淋巴结减少。患者后续接受了放射治疗,进一步减少了肺部病变和转移淋巴结。
8个月后,CT影像学检查发现这名高加索病人的病人进展,肺部结节开始变大,但是肺部的淋巴结似乎又很稳定。由于复发的时间间隔较短,以及病人临床治疗史,这名病人不能再次化疗了。
这名病人开始了厄洛替尼(特罗凯)的二线治疗,每天的计量是150mg,特罗凯治疗4个月之后CT显示肺部病灶体积减少。

患者继续使用特罗凯进行治疗,四个月之后的CT影像学检查发现左肺下叶肿瘤显著缩小,至7毫米。

在最后一次CT影像学扫描,左肺下叶导致呼吸困难的区域还能辨识的出来,但是实体肿瘤几乎不见了,特罗凯治疗1年之后达到了完全的缓解。
可能这个疗效是即便EGFR突变的病人也难以达到的,那为何这个EGFR突变阴性的病人就达到了呢?如果这个病人最后没有盲试特罗凯,是否真就被关闭了这扇门?

研究者对患者的穿刺样本做了FISH检测,也没有发现存在EGFR基因的扩增,特罗凯治疗期间唯一的不良事件是一级皮疹,这种很早期发生的皮疹,在4周后通过局部治疗后退化,截止文章发布时病人仍在进行治疗,没有复发的迹象。
总结
现在与大家一起来回顾一下这个案例,这个患者使用特罗凯效果非常好,而且是EGFR突变阴性的。
由于之前有研究EGFR基因扩增超过一定比值,比如大于10%的癌细胞有15个以上的EGFR基因拷贝,或者大于40%的癌细胞有4个以上的EGFR基因拷贝,这样的病人对易瑞沙或特罗凯治疗反应更好。
也因为这个原因,研究者使用FISH检测了病人的基因扩增情况,不过也没有发现EGFR基因扩增。
文献报道的EGFR基因突变阴性的非小细胞肺癌病人二线治疗完全缓解的仅有两例,但是我们在很多病友中也了解有EGFR基因突变阴性,使用特罗凯或易瑞沙效果很好的情况。
之前有文章描述了这里可能的机制,比如干扰其他的信号分子等等。总之而言,如很多医生所说的,对于EGFR阴性的肺腺癌病人来说,要给予其使用TKI类靶向药物的机会,虽然不是在一线使用,但是二线或三线还是要考虑一下的,万一真如本文所述的情况,那该是多好的一个幸运。
我们最后来推理一下,这个病人究竟会是什么情况呢?如果当初他们使用二代基因检测技术检测了很多基因,按照逻辑可以测到驱动肿瘤的基因突变,如果发现是很罕见的基因突变,那么是不可能推荐特罗凯治疗的,这种情况下我们给病人下的判定是否永远剥夺了病人使用“特罗凯”并万一有效的机会呢。
面对肿瘤这个复杂的疾病,或者我们真的不能将任何问题绝对化。怀有敬畏之心地审视它,我们才能慢慢地了解,并最终战胜它。
参考文献
Maria Giuseppa Vitale, et al., Erlotinib-induced complete response in a patient with epidermal growth factor receptor wild-type lung adenocarcinoma after chemotherapy failure: a case report,J Med Case Rep. 2014; 8: 102.